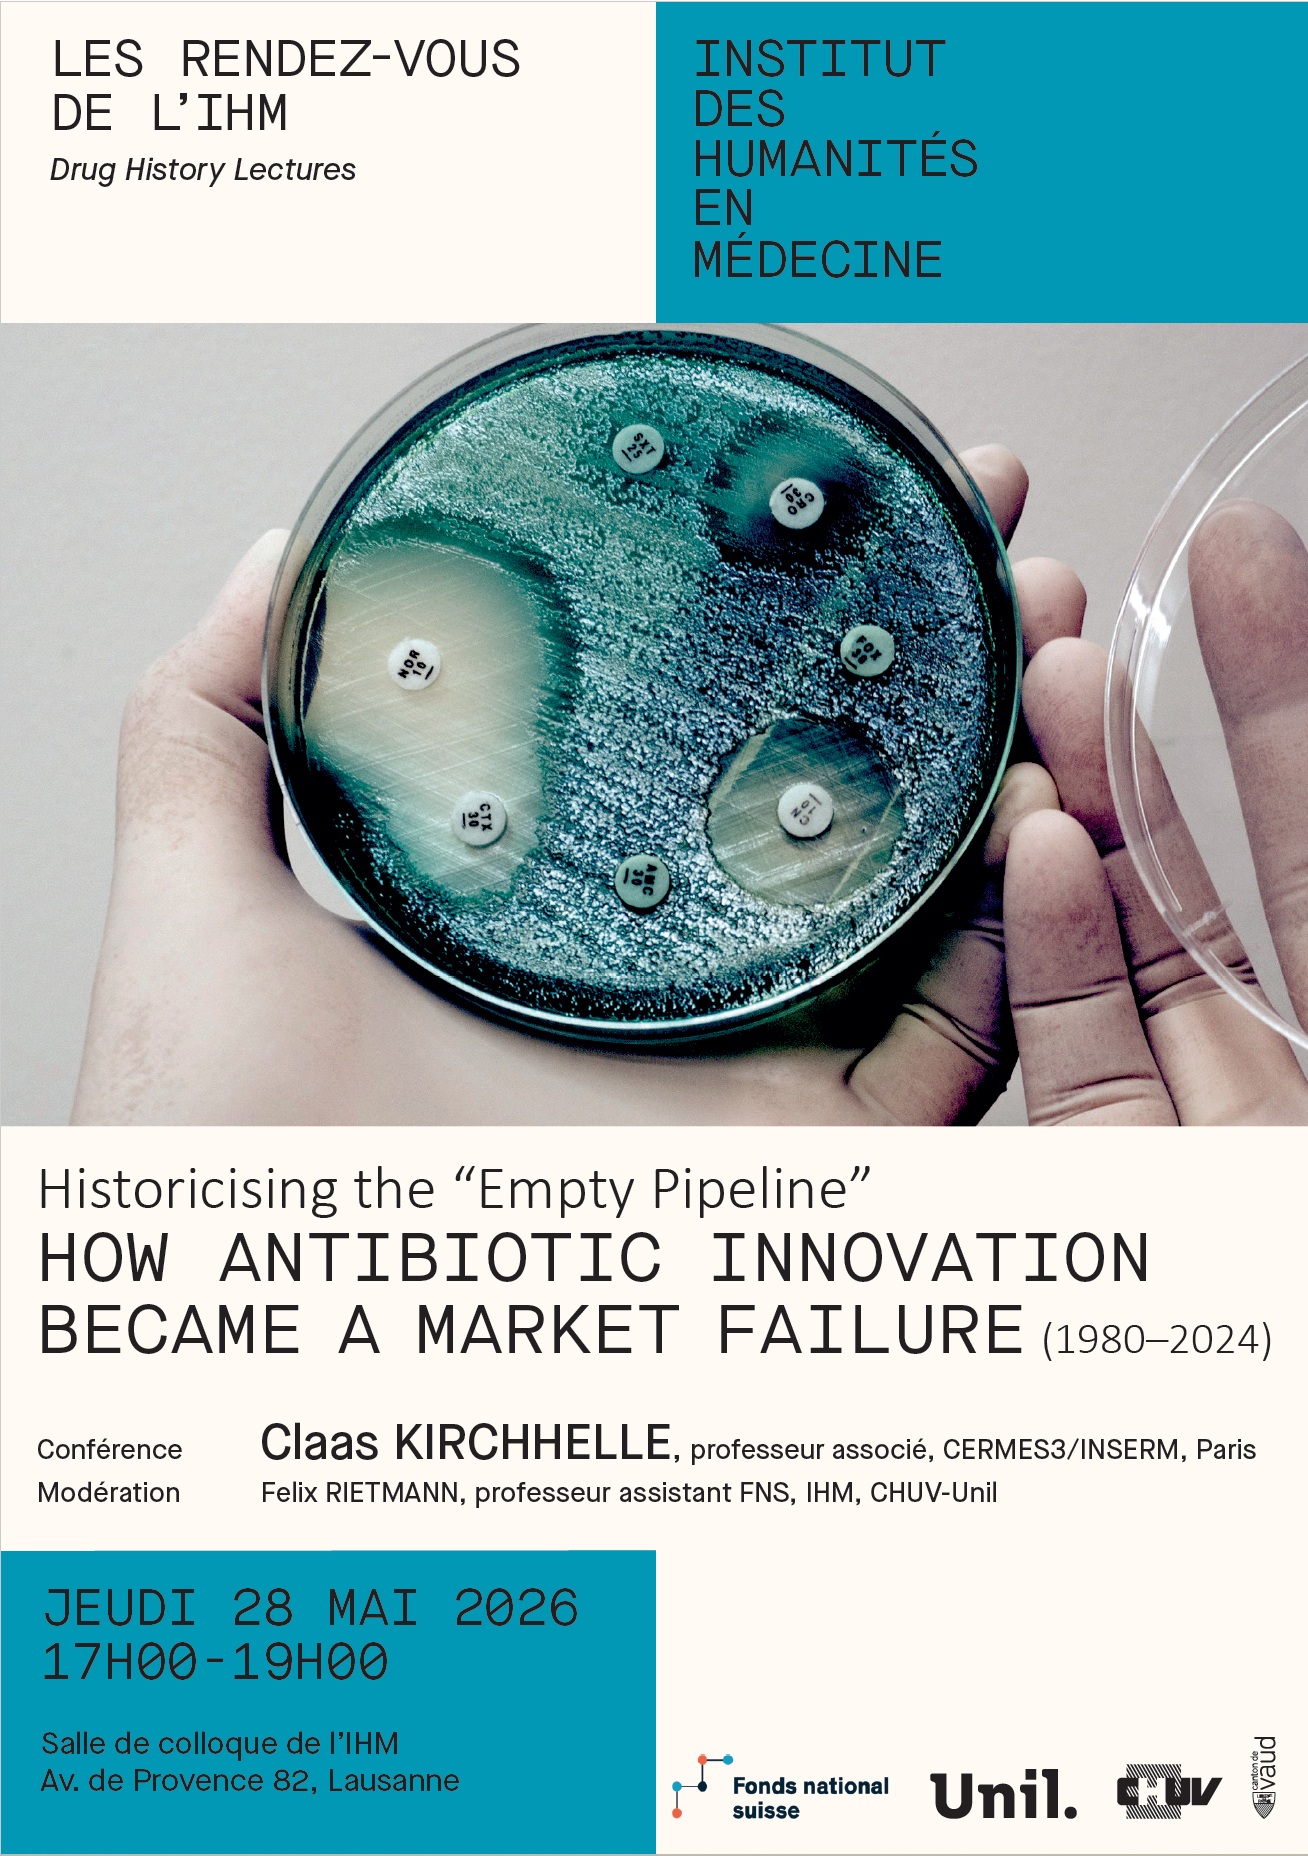

Les Rendez-vous de l’IHM sont destinés aux enseignants, chercheurs et cliniciens, aux doctorants et étudiants, ainsi qu’à toute personne intéressée par les questions abordées par les sciences humaines et sociales de la médecine et de la santé.
La participation des doctorant.e.s aux événements de l'IHM est créditée par l’École doctorale de la Faculté de biologie et de médecine de l'UNIL. Environ 20 heures suivies donnent droit à 1 ECTS.

Auditoire Mathias Mayor, CHUV, Lausanne
Laennec
Conférence et discussion autour du livre paru aux éditions BHMS (2026) Laennec. L’invention du diagnostic moderne
Conférence de Jacalyn Duffin, médecin hématologue et historienne, professeure émérite de l’Université Queen’s, Canada
Discussion avec David Gachoud, médecin associé au Service de médecine interne du CHUV et Maître d’enseignement et de recherche à la FBM-Unil, auteur de la postface de l'édition française du livre
Lien de la visioconférence (code : 280426)

Salle Amphipôle - 338
Séminaire Masculinités, santé, genre.
Aux intersections des savoirs et des pratiques sur les corps
Jonathan Saha, University of Durham
The Rise and Fall of the Jungle-Wallah: The Career of a Masculine Archetype in Colonial Myanmar
Shannon Philip, University of Cambridge
Postcolonial Machismo: Transforming Masculinities in a ‘New’ India
Modération : Ali Alrifae, Institut des humanités en médecine, Unil-CHUV
Pour suivre le séminaire en ligne, merci de contacter Francesca.Arena@unige.ch.
Le séminaire est le fruit d'un partenariat entre iHE2; Maison de l’histoire; CMCSS; Département d’histoire (UNIGE); IHM CHUV-Unil; la PlaGe, UNIL; Unisanté; FNS.

Auditoire A, Hôpital des enfants du CHUV
Éthique Clinique | Série Hors-Norme
1/3 Capacité de discernement : enjeux éthiques dans les situations complexes en psychiatrie communautaire
Intervenants :
Dr PD-MER Stéphane Morandi, chef a.i. du Service de psychiatrie sociale et communautaire, DP CHUV
Prof. Bernard Schumacher, coordinateur de l’Institut interdisciplinaire d’éthique et droits de l’homme (IIEDH), Université de Fribourg
Modération :
Marie-Claude Grivat, adjointe du médecin cantonal, Office du médecin cantonal, Direction générale de la santé de l’État de Vaud
Dr Brenda Bogaert, responsable de recherche en éthique de la santé, IHM
La série est co-organisée par le Pôle d'éthique clinique de l'Office du médecin cantonal (DSAS, État de Vaud) et l'IHM.
Salle de colloque IHM, av. de Provence 82, Lausanne
Historicising the "Empty Pipeline" | How Antibiotic Innovation Became A Market Failure
Conférence de Claas Kirchhelle, historien et professeur associé au CERMES3/INSERM, Paris, dans le cadre des « Drug History Lectures » et du projet FNS Pediatric Drugs
Organisation et modération : Felix Rietmann, IHM, CHUV-UNIL

Café du Musée de la main Unil-CHUV, Lausanne
Vernissage du livre "Les Exclus de la santé"
Ouvrage collectif de l'IHM aux éditions RMS (avril 2026), sous la direction de Salvatore Bevilacqua, Ralf J. Jox, Elena Martinez, Laurence Monnais et Béatrice Schaad
Le vernissage donnera la parole a des personnalités du monde politique et de la santé, le programme est en cours de préparation.
Il se clôturera par un apéritif convivial.

Auditoire Charlotte Olivier, CHUV
Leçon inaugurale de la Professeure Aude Fauvel
Aude Fauvel a été nommée professeure associée à la Faculté de biologie et de médecine de l'UNIL dès le 1er août 2025. Sa Leçon sera précédée d’une introduction par le Prof. Ralf Jox, directeur de l'IHM.
Entrée libre. La manifestation sera suivie d'un apéritif.


Salle 2235, Géopolis, Unil
Maladies médicalement invisibles.
La tyrannie des diagnostics et les assurances
Conférence publique de Ilana Löwy, historienne des sciences et directrice de recherche à l'INSERM (Paris)
Discutante : Marjolaine Viret, professeure au Centre de droit comparé, européen et international (FDCA, Unil)
Modératrices : Nolwenn Bühler, professeure à l'Institut des sciences sociales et politiques, co-directrice du STS Lab (SSP, Unil) et Laurence Monnais, professeure à l'IHM (FBM, Unil-CHUV)
Lien de la visioconférence (code : 19032026)

Aula de l’IDHEAP, UNIL
« Qui gouverne nos pensées » ?
Intelligence artificielle, neurotechnologies et intégrité cognitive : comprendre les nouveaux enjeux éthiques et sociaux
Intervenants :
Roberto Andorno, professeur en droit biomédical et bioéthique à l’Université de Zürich, ex-membre du Groupe d'experts de l'UNESCO « Éthique des neurotechnologies » (2024-2025)
Bruno Giussani, auteur (Manuel de résistance à l’emprise technologique, 2026) et ancien directeur européen des conférences TED
Modération : Béatrice Schaad et Ralf Jox, IHM, CHUV-UNIL
Entrée libre. La manifestation sera suivie d'un apéritif.
La Librairie Basta sera présente avec plusieurs ouvrages des conférenciers mis à la vente.

Salle Cinéma Paradiso, Centre de soins hospitalier (RFSM), Marsens
Patientes et patients témoins de l’histoire. Encres, traces, papiers. L’art d’écrire à l’Asile de Marsens, 1875-1900
Intervenant.es :
Jessica Schüpbach, autrice de l’ouvrage Encres, traces, papiers. L’art d’écrire à l’Asile de Marsens, 1875-1900 (BHMS, 2025), post-doctorante, Institut Éthique Histoire Humanités, UNIGE
Christophe Mauron, conservateur au Musée gruérien
Isabelle Gothuey, professeure titulaire, médecin directrice du Secteur de psychiatrie et psychothérapie pour adultes du Réseau fribourgeois de santé mentale, Marsens
Modération : Élodie Murtas, première assistante, Faculté des Lettres, UNIL
Organisation : Sarah Pflug et Alba Brizzi, IHM, Éditions BHMS

Site de Cery, Nouvel Hôpital, auditoire Aloïse Corbaz
Lieux insolites, archives extraordinaires | L'histoire hors-normes de Cery
Vernissage du livre Histoires et mémoires de Cery. (Dé)Construire la psychiatrie après 1945 (Éditions BHMS, 2025) avec Aude Fauvel et Mikhaël Moreau, IHM CHUV-UNIL, Kerstin von Plessen, Manuel Simon, Carolina Spanevello, DP-CHUV, et Mirela Bera, GRAAP.
Entrée libre. Un apéritif et un moment de dédicaces suivront l'événement.

Salle de colloque de l'IHM, avenue de Provence 82, Lausanne
Journées d'études organisées par Brenda Bogaert et Kristina Würth, IHM, CHUV-UNIL, Sigrun Eng, Norwegian Academy of Music, Oslo, et Giulia Andreini, IULM University, Milan.
L'événement se déroulera en anglais.

Le Cinématographe, Casino de Montbenon, Lausanne
Projection et débat autour du film documentaire "L'adieu à la viande. La grande histoire des végétariens", réalisé par Martin Blanchard et produit par O2B, Arte 2025
18h00 : Accueil
18h15 : Projection du film
19h45 : Débat modéré par Laurence Monnais, IHM, CHUV-UNIL, avec comme intervenant.es :
Martin Blanchard, réalisateur
Nolwenn Bühler, anthropologue, UNIL
Olivier Christin, historien, UNINE
Christine Mayor, co-fondatrice de l'association Animae
Nicolas Senn, médecin, Unisanté/UNIL
Entrée libre et gratuite.

Auditoire Mathias Mayor, CHUV
Intervenant.e.s:
Mario Beauregard, neuroscientifique, Canada
Jacques Besson, psychiatre, prof.hon. UNIL
Anne Dalle Ave, médecin et éthicienne, IHM, CHUV-UNIL & Professeure associée, Georgetown University
Les présentations seront suivies d'une discussion avec:
Pr.hon UNIL Pierre-Yves Brandt, ancien professeur de psychologie des religions à la FTSR
Pr.hon. UNIL Stéphanie Clarke, ancienne cheffe du Service de neuropsychologie du CHUV
Dr. Etienne Rochat, chercheur en santé et spiritualité, IHM, CHUV-UNIL
Pr.hon. UNIL Marie-Denise Schaller, ancienne cheffe du Service de médecine intensive du CHUV
Modération : Dr Jean-Daniel Rouvé, Service d'anesthésiologie, CHUV

Salle de colloque de l’IHM
Conférences de Brenda Bogaert, IHM, CHUV-UNIL, et Joëlle Schwarz, Unité santé et genre, Unisanté
Modération : Ralf J. Jox, IHM, CHUV-UNIL
Cet événement est organisé à l’occasion du vernissage du livre de Brenda Bogaert Affective Injustice in Healthcare, Springer Verlag 2025

Salle de colloque de l'IHM, avenue de Provence 82, Lausanne
Intervenantes:
Anne-Sylvie Diezi, responsable pôle information et expérience patient du CHUV et doctorante au Lausanne Perinatal Research Group, IUFRS, UNIL-CHUV
Anne-Isabelle Thuysbaert, doctorante PhD, Université catholique de Louvain
Modération:
Frédéric Erard, IHM & FDCA, UNIL

Auditoire Mathias Mayor, CHUV
Séminaire organisé par Lucia Candelise, Institut des sciences sociales, UNIL ; Laurence Monnais, IHM, CHUV-UNIL ; et Pascale Schmied, docteure en médecine chinoise et membre affiliée à l’IHM
Programme:
Pascale Schmied. Comment l’histoire et l’anthropologie de la médecine enrichissent et éclairent notre pratique de l’acupuncture
Frédéric Obringer, EHESS, Paris. Les premiers pas de l’acupuncture en France au début du XIXe siècle
Lucia Candelise. Entre itinéraires individuels et tentatives d’institutionnalisation. La circulation de l’acupuncture entre France et Suisse au XXe siècle
Dre Caitriona Ungarelli-McEvoy, Centre de médecine intégrative et complémentaire, CHUV. Intégration de l’acupuncture dans le milieu hospitalier : l’exemple du CHUV
Conclusions : Laurence Monnais, Pascale Schmied, Lucia Candelise

Auditoire Charlotte Olivier, CHUV
Intervenant.es
Helmut Gassner, moine bouddhiste au Centre tibétain du Mont-Pèlerin
Pascale Hancart Petitet, anthropologue de la santé, TransVIHMI, Institut de recherche pour le développement, INSERM, Université de Montpellier
Etienne Rochat, Axe santé et spiritualité, IHM, CHUV-UNIL
Discutant
Pierre-Yves Brandt, Professeur honoraire de l’UNIL en psychologie de la religion

Salle de colloque de l'IHM, av. de Provence 82, Lausanne
Journée d’étudesorganisée par Ali Alrifae, IHM CHUV-UNIL, et Guillaume Linte, CNRS, Université Aix-Marseille
Intervenant.e.s
Ali Alrifae, IHM, CHUV-UNIL
Mady Barbeitas, CNRS-LISIS / Casa de Oswaldo Cruz – Fiocruz
Fleur Beauvieux, Aix-Marseille Université
Hannah De Korte, KU Leuven / Maastricht University
Kevin Dzi, IHM, CHUV-UNIL
Aude Fauvel, IHM, CHUV-UNIL
Amel Fillali, Unisanté
Pascale Hancart Petitet, IRD, Université de Montpellier
Lou Laval Matip, Aix-Marseille Université
Guillaume Linte, CNRS, Université d’Aix-Marseille
Naïma Maggetti, Maison de l’histoire, UNIGE
Laurence Monnais, IHM, CHUV-UNIL
Shiori Nosaka, EHESS, Paris
Gildas Igor Noumbou Tetam, UNIL
Amélie Puche, IHM, CHUV-UNIL
Cette journée d’étude traite de la notion de négligence en santé dans une perspective historique, à partir de cas d'étude relatifs à des contextes (post-)coloniaux et dans la longue durée. Elle souhaite aussi ouvrir un échange interdisciplinaire autour de cet enjeu toujours très actuel.
L’événement bénéficie du soutien financier de la Commission EDI de la Faculté de biologie et de médecine et de la Plateforme en études genre (PlaGe) de l’UNIL.
Programme de la journée d'études

IHM, av. de Provence 82, Lausanne
Conférence de Irene Maffi, professeure d’anthropologie de la santé à l’UNIL, est co-auteure du livre : Allaiter. Histoire(s) et cultures d’une pratique (2023, Brepols)
Visite commentée de l'exposition en présence de l’artiste Jagoda Wisniewska, et de Laurence Monnais, Céline Fischer Fumeaux et Magdalena Czartoryjska Meier.
L’événement sera suivi d’un apéritif. Entrée libre sans inscription.

Panel Sessions and Roundtable at the Swiss Pavilion of the Osaka World Exposition 2025
Speakers: Murielle Bochud Unisanté & University of Lausanne (CH), Brenda Bogaert Institute of Humanities in Medicine, Lausanne University Hospital CHUV & University of Lausanne (CH), Nolwenn Bühler Institute of Social Sciences, University of Lausanne (CH), Ludovico Cobuccio Lausanne University Hospital CHUV (CH), Pierre-Yves Donzé University of Osaka (JP) & University of Fribourg (CH), Mariama Kaba Institute of Humanities in Medicine, Lausanne University Hospital CHUV & University of Lausanne (CH), Hitoshi Oshitani Tohoku University (JP), Akihito Suzuki University of Tokyo (JP), Chuangwei Zheng University of Tokyo (JP)
Organization: Mariama Kaba and Brenda Bogaert Institute of Humanities in Medicine, Lausanne University Hospital CHUV & University of Lausanne (CH)
Organisation : Elena Martinez, IHM